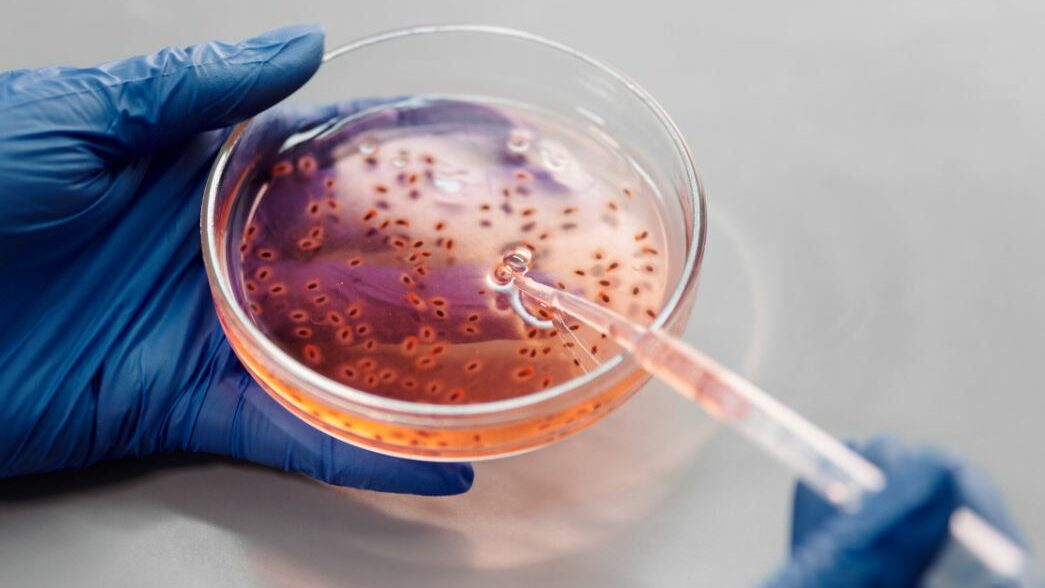
Mains gantées tenant une boîte de Pétri avec un liquide et une pipette.

Les personnes trans et le Sport
Depuis toujours, le sport fait partie de la culture mondiale. La majorité des gens le pratiquent comme passe-temps. D’autres, le font pour des raisons professionnelles. Pour la plupart de ces activités sportives, on constate l’existence de compétitions. Et dans ces compétitions, il y a des gagnants, des seconds et divers classements.
C’est pourquoi, lorsque les personnes trans ont commencé à revendiquer leurs droits fondamentaux, le débat concernant leur participation dans le sport en tant qu’athlètes transgenres a fait l’objet de controversés. Le sport vise à promouvoir la discipline et l’esprit sportif, à divertir et à améliorer la vie. Cependant, certaines traditions ne s’accordent pas bien avec l’inclusion sociale.
Sur cette page
Différences entre les genres dans le sport
Étant donné que vous connaissez déjà les fondements du sport, il est temps de discuter de certaines distinctions. Traditionnellement, les sports de compétition et les événements sportifs imposent une certaine division. Il s’agit de la séparation des compétitions en fonction du genre.
Naturellement, la plupart des hommes sont plus forts que les femmes sur le plan physique. C’est pourquoi, afin d’intégrer l’équité dans les compétitions, les hommes ont été séparés des femmes. Il y a :
- la NBA (pour les hommes) et la WNBA (pour les femmes) ;
- la NFL (pour les hommes) et la WNFL (pour les femmes) ;
- et bien d’autres encore.

Lorsque les personnes transgenres, et plus particulièrement les femmes trans, ont commencé à retrouver leurs droits fondamentaux, cela a eu un impact sur le domaine du sport. De nombreuses personnes sont en désaccord avec le fait que les femmes transgenres participent aux compétitions sportives féminines.
Ils disent que les femmes cisgenres sont désavantagées parce que les femmes trans sont naturellement plus fortes et plus rapides. Bien que cet argument soit valable, il a également cimenté l’exclusion des femmes transgenres des compétitions sportives nationales.
Les athlètes transgenres
Les débats sur l’inclusion des femmes transgenres dans le sport féminin mènent au sujet des hormones et de la force physique. Certains compromis ont été constatés.
Pour des raisons d’équité, certains événements sportifs vérifient les niveaux d’hormones des femmes transgenres avant le début des jeux. Si leurs taux hormonaux sont dans la fourchette des taux féminins, les organisateurs permettent aux femmes trans de se mesurer aux femmes cisgenres.

Cependant, tous les organisateurs d’événements sportifs ne sont pas ouverts à ce genre d’idée. De plus, la majorité des amateurs de sport ne trouvent pas ce type de mesure équitable pour les femmes cisgenres.
Actuellement, en 2021, aucune norme n’a encore été fixée pour permettre aux femmes trans de participer à des événements sportifs féminins. Il n’y a pas non plus eu de progrès dans la création de sections sportives réservés aux personnes trans. Mais cela ne veut pas dire que les athlètes transgenres n’existent pas déjà.
Les compétitions sportives pour les personnes trans en 2021
Cette année encore, la prise de fonction du président Joe Biden a constitué un point positif. Il a promulgué un décret visant à inclure toutes les athlètes féminines transgenres dans les événements sportifs.
Ledit décret vise à prévenir et à combattre la discrimination fondée sur l’identité de genre ou l’orientation sexuelle. Il a été signé le jour de son inauguration. L’un des décrets, destiné aux établissements d’enseignement qui reçoivent des fonds du gouvernement, vise à permettre aux personnes qui s’identifient comme femmes de rejoindre les équipes sportives féminines à l’école.
Ce n’était cependant pas ce que certaines personnalités féminines voulaient entendre. Il s’agit de figures emblématiques du sport féminin, dont Martina Navratilova, qui a participé à de nombreux Jeux olympiques et est une légende du tennis.
L’approche scientifique
Tout cela ne signifie pas qu’ils protestent contre l’ordre exécutif de manière infondée. Nancy Hogshead-Makar, avocate et l’une des représentantes du « Women’s Sports Policy Working Group » déclara :
Nous soutenons pleinement le décret de Biden, qui met fin à la discrimination des personnes LGBT dans l’ensemble de la société, y compris en matière d’emploi, de banque, de droit de la famille et de logement public. Les sports de compétition rappellent toutefois les tests de grossesse et les tests médicaux ; ces domaines nécessitent une approche scientifique de l’inclusion des personnes transgenres. Notre objectif a été de protéger les catégories compétitives des filles et des femmes, tout en intégrant dans le sport, dans la mesure du possible, les athlètes trans.
La position du Comité international olympique sur les athlètes transgenres
En 2015, la politique de l’ICO (International Olympic Committee ou Comité international olympique en Français), stipule que les femmes trans peuvent concourir dans les sports féminins si elles suppriment leur taux de testostérone pendant 12 mois à l’aide d’un traitement.
Aujourd’hui, ils pensent changer la politique pour inclure toutes les athlètes féminines pour correspondre à un certain niveau de testostérone.
Le sport au lycée pour les jeunes athlètes trans
Il existe de nombreux débats sur le fait de savoir si les adolescents trans peuvent ou non pratiquer des sports féminins dans les écoles secondaires.
Beaucoup pensent que les filles trans ont un avantage injuste par rapport aux filles cis, alors qu’un entraîneur de lycée à la retraite affirme le contraire.
Selon Larry Strauss, professeur d’anglais et entraîneur de basket-ball à la retraite à South Los Angeles :
dans la vraie vie, les filles trans dans le sport ne sont pas une controverse – nous avons tardivement cessé d’exclure les athlètes de couleur du sport au lycée et à l’université. Combien d’années encore les gens vont-ils essayer d’exclure les athlètes transgenres ?
Ce que la Présidence de Joe Biden implique
Bien que l’objectif d’inclusion de Joe Biden soit noble, certains protocoles doivent être respectés. Les sports sont très compétitifs et les gagnants doivent être annoncés sur la base:
- de l’équité ;
- des mérites ;
- du travail acharné.
Les conditions de jeu doivent également être égales pour les femmes trans afin que la transition vers le sport féminin se fasse en douceur.

Actuellement, tout est flou en ce qui concerne son décret. Tout comme ce que Hogshead-Makar ajouta :
Bien que les détails du décret du président Biden restent flous, demander aux femmes – non, leur exiger – de renoncer à leurs droits durement acquis de concourir et d’être reconnues dans le sport d’élite, avec l’égalité des chances, des bourses, des récompenses, de la publicité, de l’honneur et du respect, ne rend pas service à la cause de l’inclusion des transgenres.
Elle ajouta en disant :
Cela engendre un ressentiment justifiable, faisant reculer la cause de l’égalité dans toute la société. Et toute position extrême – inclusion totale ou exclusion totale dans le sport – rendra la vie beaucoup plus difficile aux personnes transgenres. Nous devons faire du sport un espace accueillant pour tous.
Athlètes Trans Célèbres
Au milieu de toute cette confusion et de ce chaos, les athlètes transgenres existent bel et bien. Certains d’entre eux sont même des champions olympiques.
Caitlyn Jenner
Elle est probablement l’une des athlètes transgenres les plus populaires de tous les temps, si ce n’est la plus populaire. Elle n’a cependant pas obtenu ses médailles d’or olympiques après la transition. Son premier succès olympique remonte à 1974. La même année, elle remporta sa première victoire dans une épreuve de décathlon masculin.
Elle a également décroché la première place aux Jeux panaméricains et aux Jeux olympiques de 1974 et 1975 respectivement.
En raison de la notoriété qu’elle a acquise grâce à ses succès au décathlon, elle est devenue porte-parole de la marque de céréales pour petit déjeuner Wheaties dans les années 70. Elle est également apparue dans diverses émissions de télévision et de cinéma à la même époque.

Aujourd’hui, elle est surtout connue pour avoir fait son coming out controversé en tant que femme transgenre. Elle l’a fait tout en continuant Keeping up with the Kardashians et en étant connue comme le patriarche de la famille.
De nombreuses réactions ont été négatives, mais ce fut une victoire pour la communauté transgenre. En raison de la grande audience de l’émission de télé-réalité, son histoire a pu atteindre un nombre impressionnant de personnes. Son courage a ouvert les yeux de nombreuses personnes pour qu’elles s’informent sur ce qui sont les personnes trans.
Suivez Caitlyn Jenner: Facebook | Instagram | Youtube | IMDb
Chris Mosier
Mosier a commencé sa carrière d’athlète avant de devenir un homme. En 2015, il a pu prendre une place dans l’équipe masculine de duathlon sprint Team USA pour le Championnat du monde de 2016. Il est devenu célèbre après avoir été le premier athlète ouvertement transgenre membre d’une équipe nationale américaine.

Son parcours professionnel ne s’est pas arrêté à sa propre carrière. Il est également le fondateur de transathlete.com. Le site web est une ressource pour les athlètes, les entraîneurs, les étudiants et les administrateurs trans pour découvrir les dernières informations sur la trans-inclusion dans le monde du sport.
Il travaille également avec différentes organisations sportives pour renforcer l’inclusion des athlètes trans dans le monde du sport. En 2020, Mosier a participé aux essais de l’équipe olympique américaine pour la course de 50 km. Il n’a pas été classé parce qu’il se blessa pendant la course.
Suivez Chris Mosier: Facebook | Instagram | Threads | Youtube | TikTok | Site Officiel
Lia Thomas
C’est probablement l’une des athlètes trans les plus controversées d’aujourd’hui. Lia Catherine Thomas, la première athlète ouvertement transgenre à avoir remporté un championnat national NCAA, a suscité de nombreux débats concernant les femmes transgenres dans le sport.

Thomas a remporté l’épreuve du 500 mètres nage libre féminin, ce qui a amené beaucoup de gens à se demander si sa victoire était juste. Fox News, ainsi que plusieurs médias religieux, ont couvert la question des parents anonymes des membres de l’équipe de natation de l’université de Pennsylvanie demandant à l’institution de la déclarer inéligible à la compétition.
Brooke Forde, médaillée d’argent olympique, a déclaré à propos de Thomas :
Je crois que traiter les gens avec respect et dignité est plus important que n’importe quel trophée ou record, c’est pourquoi je n’aurai aucun problème à courir contre Lia aux NCAA cette année.
Une autre nageuse, la médaillée d’argent olympique Erica Sullivan, a apporté son soutien à Thomas dans un article d’opinion pour Newsweek en déclarant :
Comme n’importe qui d’autre dans ce sport, Lia s’est entraînée avec rigeur pour arriver là où elle est et a suivi toutes les règles et directives qui lui ont été imposées… elle ne gagne pas à tous les coups. Et quand elle gagne, elle mérite, comme n’importe qui d’autre dans ce sport, d’être célébrée pour son succès durement gagné, et non d’être étiquetée comme tricheuse simplement en raison de son identité.
Suivez Lia Thomas: Instagram
Renee Richards
Contrairement à Jenner, Richards a pu gagner des événements sportifs tout en se mesurant à des femmes cisgenres. Elle est ophtalmologiste et ancienne joueuse de tennis. Sa carrière d’athlète lui a permis de se distinguer sur le circuit sportif professionnel des années 70.
Elle est surtout connue pour s’être battue pour pouvoir participer à l’US Open en 1976 après avoir subi une opération d’affirmation de genre.

Elle a été révélée en tant que femme trans par un présentateur de télévision local nommé Richard Carlson en 1976. Pour cette raison l’Association américaine de tennis (USTA), le Comité de l’Open des États-Unis (USOC) et l’Association féminine de tennis (WTA) ont imposé aux concurrentes de se soumettre à une vérification par le biais de tests chromosomiques.
Richards refusa le test et ne fut pas autorisée à participer à l’Open de Wimbledon en 1976. Par la suite, elle a poursuivi l’USTA pour discrimination sexuelle en violation de la loi new-yorkaise sur les droits de l’homme. Pour cette raison, elle fut autorisée à jouer à l’US Open en 1977.
Le Futur des Athlètes Transgenres
Certains disent qu’il devrait y avoir des compétitions sportives transgenres. Cependant, cela va à l’encontre de la lutte pour l’inclusion que les personnes trans méritent. De nombreuses discussions et débats ont lieu actuellement car il y a de très bons arguments pour et contre l’idée. L’inclusion des athlètes transgenres a encore beaucoup de progrès à faire.
Si vous souhaitez ouvrir un débat sain entre vos amis, partagez cet article.